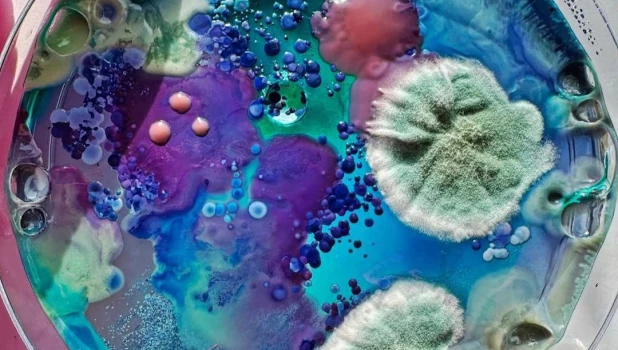
Девушки создают биопортреты, используя микробы из подмышек, пупков и ноздрей.

Боипортреты из плесени делает московская художница-биолог. Она берет специальную палочку, похожую на ту, что используют для тестов на ковид, и собирает микробы с кожи клиенток — лица, шеи, области вокруг носа, подмышек и пупка. Это обычные обитатели нашей кожи — бактерии, грибки и вирусы.
Далее она высаживает собранные микроорганизмы в чашку Петри, добавляет краски и мелкие предметы, иногда даже любимые средства косметики, создавая яркую картину из плесени. Для долговечности все заливается эпоксидной смолой.

Пользователи соцсетей отмечают, что процесс больше напоминает творчество, нежели настоящую биохимию, однако девушки охотно платят за такие портреты около 314 тыс. рублей.
Ранее подростки начали обжигать себя из-за опасного тренда в Tik-Tok.